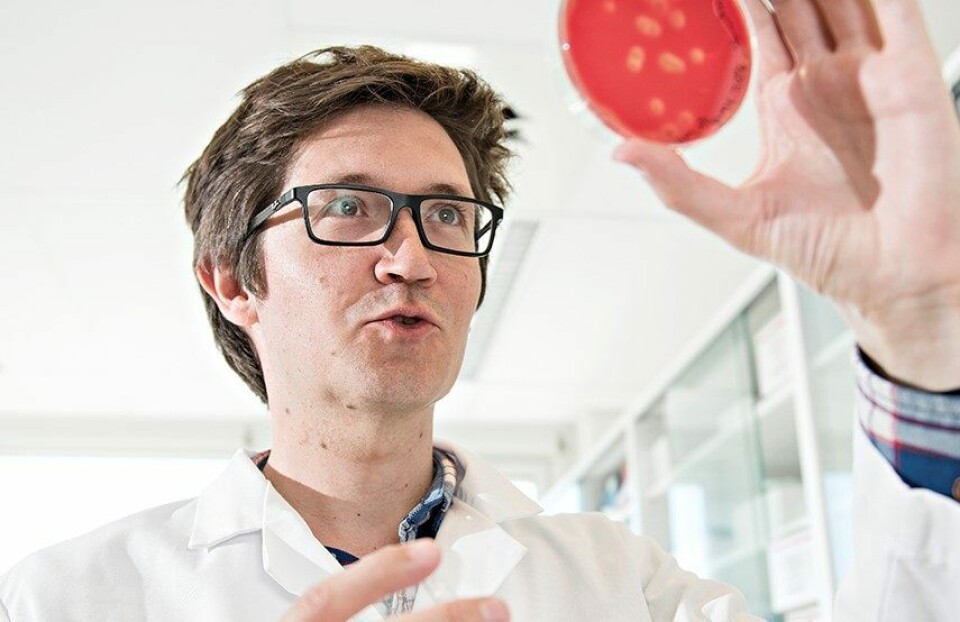

Mot sikrere utsett for laks
Økt kunnskap om laksens barrierefunksjoner i postsmoltfasen kan føre til bedre fiskehelse og spare oppdrettsnæringen for millioner.
Denne artikkelen er tre år eller eldre.
Nofima skriver på sin hjemmeside at det er anslått at 10–20 prosent av all oppdrettslaks i Norge dør mellom utsett og slakt, hvorav en betydelig andel går tapt i postsmoltfasen. Årsaken er blant annet at barrierefunksjonene til laksen svekkes i perioden etter utsett, og bruker lang tid på å gradvis hente seg inn igjen.
– Den første tiden i sjø er en sårbar fase, der fiskens forsvarssystem er redusert de tre første månedene. I denne perioden er fisken ekstra utsatt for skader og infeksjonssykdommer. Det er derfor viktig å forstå hvorfor og hvordan laksens barrierefunksjoner endres, og hva næringen kan gjøre for å tilpasse seg, sier Nofima-forsker Christian Karlsen.
Tynn i skinnet
Sammen med kollega Elisabeth Ytteborg, og andre forskere i CtrlAQUA, har han studert hvordan faktorer som stress, temperatur og behandling under utsett påvirker fiskens ytre barrierer.
– Resultatene fra forskningen viser at skinnet blir tynnere og får en svakere struktur i perioden etter utsett, men etter hvert som fisken tilpasser seg de nye omgivelsene stabiliserer skinnet seg igjen, sier Ytteborg.
Skånsom håndtering
Det er for tidlig å konkludere med om det er én faktor eller kombinasjoner av miljøforandringer som er skyld i svekkelsen av laksens ytre barriere.
– Ved å øke kunnskapen rundt den sensitive perioden i sjø, vil vi kunne legge til rette for hvordan fisken kan beskyttes og håndteres mer skånsomt. Sikrere utsett av fisken vil gi bedre fiskehelse og fiskevelferd og vil kunne bidra til å redusere dødeligheten vi ser i postsmoltfasen, sier Karlsen.
Når resultatene fra forskningen er klare, starter fasen med å utvikle nye håndteringsmetoder i samarbeid med industrien og laksenæringen.